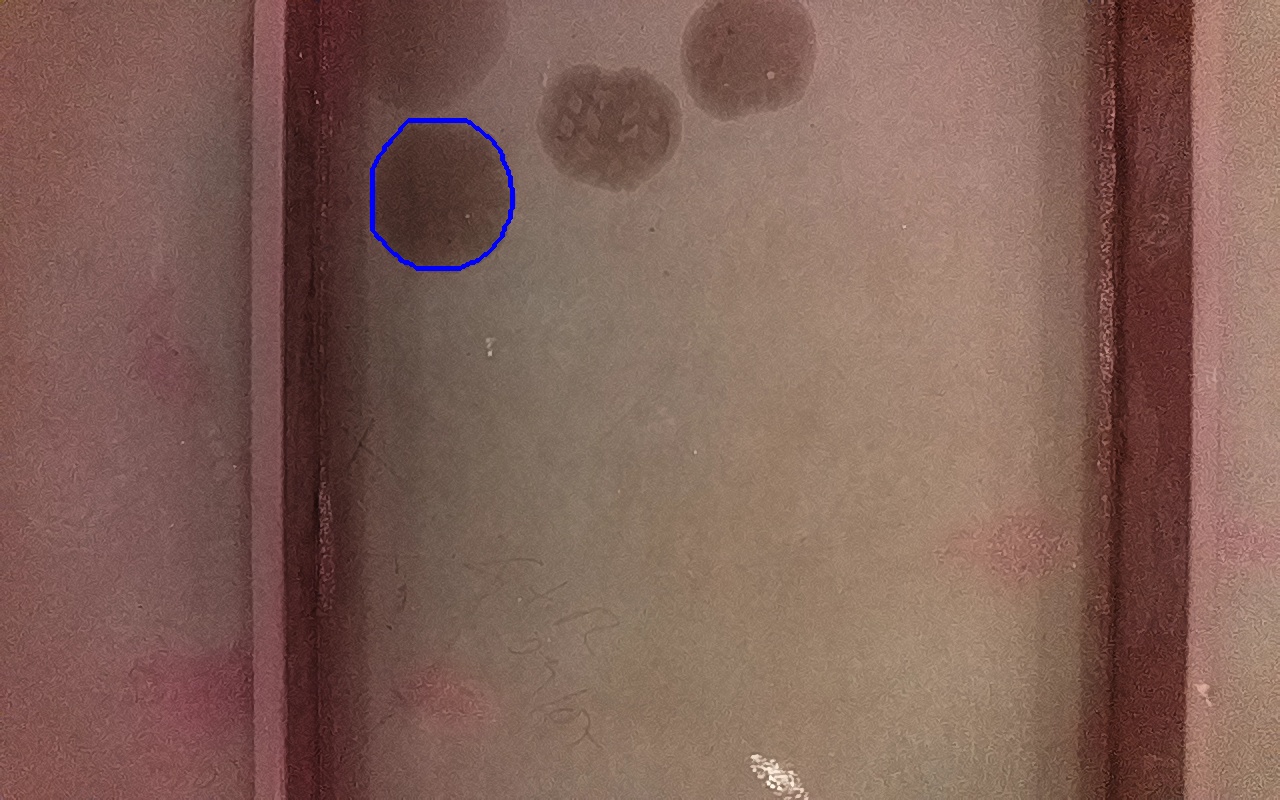

Proviene de:
IV-2
ID: 260751

Confianza: 78.87 %
6015 mm2
(x: 2.83, y: 0.01, z: 0.01)
Marcas de aceite o grasa. Suciedades o todo tipo de contaminantes solubles.
Incluído en discontinuidad final: 265600
IV-2
ID: 260762

Confianza: 72.86 %
5983 mm2
(x: 2.83, y: 0.01, z: 0.01)
Marcas de aceite o grasa. Suciedades o todo tipo de contaminantes solubles.
Incluído en discontinuidad final: 265600
IV-2
ID: 260774

Confianza: 75.64 %
6082 mm2
(x: 2.83, y: 0.02, z: 0.01)
Marcas de aceite o grasa. Suciedades o todo tipo de contaminantes solubles.
Incluído en discontinuidad final: 265600
IV-2
ID: 260783

Confianza: 69.68 %
6091 mm2
(x: 2.83, y: 0.02, z: 0.01)
Marcas de aceite o grasa. Suciedades o todo tipo de contaminantes solubles.
Incluído en discontinuidad final: 265600
IV-2
ID: 260889

Confianza: 86.9 %
10948 mm2
(x: 2.77, y: 0.02, z: 0.02)
Marcas de aceite o grasa. Suciedades o todo tipo de contaminantes solubles.
Incluído en discontinuidad final: 265600
IV-2
ID: 260897

Confianza: 87.37 %
11131 mm2
(x: 2.77, y: 0.02, z: 0.02)
Marcas de aceite o grasa. Suciedades o todo tipo de contaminantes solubles.
Incluído en discontinuidad final: 265600
IV-2
ID: 260911
Confianza: 85.74 %
10884 mm2
(x: 2.77, y: 0.01, z: 0.01)
Marcas de aceite o grasa. Suciedades o todo tipo de contaminantes solubles.
Incluído en discontinuidad final: 265600
Discontinuidad detectada
| Tipo |
IV-2
Marcas de aceite o grasa. Suciedades o todo tipo de contaminantes solubles. |
|---|---|
| Fecha | 26/06/2025 17:13 |
| Tamaño (mm) | 11131 mm2 |
| Tamaño (m) | 0.0111 m2 |
| Confianza | 87.37 % |
| Posición |
X: 2.79 Y: 0.02 Z: 0.01 |
